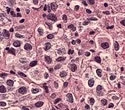

Russian gas exports are in danger because of US Due to US sanctions put in place in February that forbid the supply of any gas…
Dallas Identity
According to Russian media, the FSB border guard building is on fire in Rostov-on-Don, Russia. Before the fire started in the building on Sivers Avenue,…
The “Everything Everywhere All at Once” actress Michelle Yeoh, an Oscar winner, attended the Academy Awards on March 12 with her longtime partner Jean Todt.…
By acting as containment structures and dividing the intracellular region from the external environment, cell membranes serve a crucial role. Proteins having unique functional units…
In front of the organization’s New York City offices on Wall Street, a flag for Deutsche Bank AG is flying. Look at the businesses grabbing…
The HBO series Euphoria, which follows a group of young people struggling with adolescence and drug and sex experimentation, has utterly captivated Gen Z and…
After official data revealed that UK inflation unexpectedly increased to 10.4% a year in February, the Monetary Policy Committee approved the widely anticipated move to…
It is no longer a secret that Bruce Willis, Demi Moore, and Emma Heming Willis all make excellent parents. When it comes to family concerns,…
New psychological thriller series “Saint X,” which debuted on Hulu on April 26 and will be available on Disney+ in the UK on June 7,…
Chicago will elect a new mayor in less than two weeks. Why it matters: Whoever wins the job—Paul Vallas or Brandon Johnson—will introduce new programs…